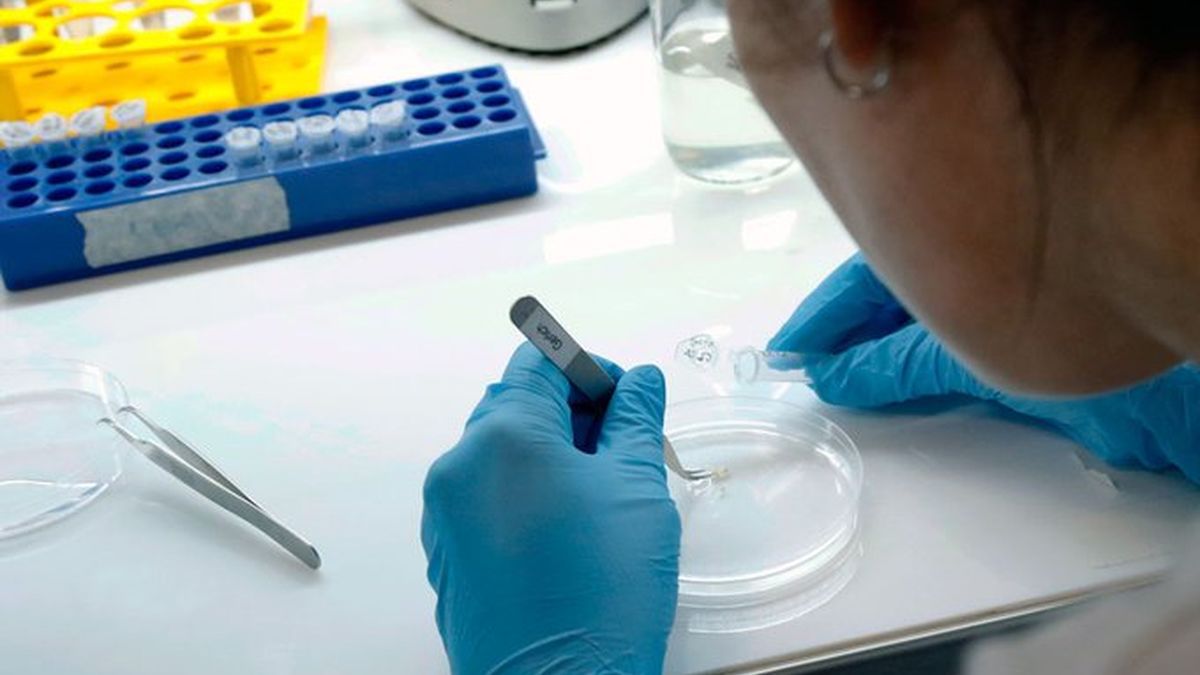

El Chaco finaliza este viernes 24 de julio la última instancia de cuarentena estricta, antes del inicio del plan de desescalada, con 63 nuevos casos de coronavirus registrados en las últimas 24 horas, por lo que el total de infectados ascendió a 3.218, según el último parte epidemiológico del Ministerio de Salud de la Nación.
Además, de acuerdo a los últimos datos oficiales de la cartera sanitaria provincial, el número de víctimas fatales desde el inicio de la pandemia es de 133, tras las cinco muertes registradas en la mañana de este viernes.
Con estos números, el Chaco sigue siendo el tercer distrito del país con mayor cantidad de casos de coronavirus en el país.
Confirmaron 5.493 nuevos contagios en la Argentina
El Ministerio de Salud informó este viernes 5493 nuevos casos de coronavirus y 105 muertes en las últimas 24 horas en la Argentina. Así, el total de infectados en todo el país son 153.520 y las víctimas fatales, 2807. En tanto, ya hay 65.447 personas que se recuperaron de la enfermedad.
En total, se conocieron 3790 nuevos casos en la provincia de Buenos Aires, 1157 en la Ciudad, 155 en Jujuy, 63 en Chaco, 56 en Córdoba y Mendoza, 40 en Río Negro, 38 en Santa Cruz, 37 en Tierra del Fuego, 32 en Santa Fe, 18 en Neuquén, 13 en Salta, 11 en Entre Ríos, 10 en La Rioja, 6 en Chubut, 4 en Tucumán, 2 en Formosa y Santiago del Estero y uno en Misiones, San Juan y San Luis.
Así, el territorio bonaerense es el área con mayor número de infectados (88.709 totales), seguido por la capital del país (51.977) y Chaco (3218). En tanto, este jueves no se registraron contagios en Catamarca, Corrientes y La Pampa.
Hubo 105 muertes en las últimas 24 horas
La cartera sanitaria nacional reportó 105 muertes por coronavirus, por lo que el total de fallecidos en el país desde el inicio de la pandemia suman 2.807. En el reporte matutino ya se habían reportado 20 muertes: 11 hombres (7 de la provincia de Buenos Aires, 3 de la ciudad de Buenos Aires, y uno del Chaco); y 9 mujeres (5 residentes en la provincia de Buenos Aires; 1 residentes en la ciudad de Buenos Aires; 2 residentes en la provincia de Chaco; y una residente en la provincia de Río Negro).
En el informe vespertino se comunicaron 85 fallecimientos más: 40 hombres (32 residentes en la provincia de Buenos Aires; 8 residentes en la ciudad de Buenos Aires); y 45 mujeres (36 residentes en la provincia de Buenos Aires; 7 residentes en la ciudad de Buenos Aires; 1 residente en la provincia de Córdoba; y 1 residente en la provincia de Mendoza).
Fuente: datachaco.com